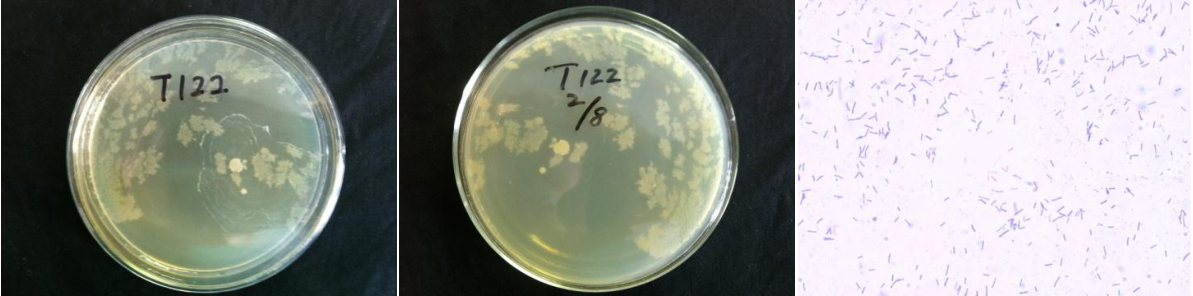

Loading...
| StrainNO | B393 |
| Classification | Paenibacillus |
| 16s rDNA sequence | CCCTGGCGCGTGCCTATACATGCAGTCGAGCGGACTTGATGGAGTGCTTGCACTCCTGATGGTTAGCGGCGGACGGGTGAGTAAC ACGTAGGCAACCTGCCCTCAAGACTGGGATAACTACCGGAAACGGTAGCTAATACCGGATAATTTATTTCGCAGCATTGTGGAAT AATGAAAGACGGAGCAATCTGTCACTTGGGGATGGGCCTGCGGCGCATTAGCTAGTTGGTGGGGTAACGGCCCACCAAGGCGACG ATGCGTAGCCGACCTGAGAGGGTGAACGGCCACACTGGGACTGAGACACGGCCCAGACTCCTACGGGAGGCAGCAGTAGGGAATC TTCCGCAATGGGCGAAAGCCTGACGGAGCAACGCCGCGTGAGTGATGAAGGTTTTCGGATCGTAAAGCTCTGTTGCCAAGGAAGA ACGTCTTCTAGAGTAACTGCTAGGAGAGTGACGGTACTTGAGAAGAAAGCCCCGGCTAACTACGTGCCAGCAGCCGCGGTAATAC GTAGGGGGCAAGCGTTGTCCGGAATTATTGGGCGTAAAGCGCGCGCAGGCGGTTCTTTAAGTCTGGTGTTTAAACCCGAGGCTCA ACTTCGGGTCGCACTGGAAACTGGGGGACTTGAGTGCAGAAGAGGAGAGTGGAATTCCACGTGTAGCGGTGAAATGCGTAGATAT GTGGAGGAACACCAGTGGCGAAGGCGACTCTCTGGGCTGTAACTGACGCTGAGGCGCGAAAGCGTGGGGAGCAAACAGGATTAGA TACCCTGGTAGTCCACGCCGTAAACGATGAATGCTAGGTGTTAGGGGTTTCGATACCCTTGGTGCCGAAGTTAACACATTAAGCA TTCCGCCTGGGGAGTACGGTCGCAAGACTGAAACTCAAAGGAATTGACGGGGACCCGCACAAGCAGTGGAGTATGTGGTTTAATT CGAAGCAACGCGAAGAACCTTACCAAGTCTTGACATCCCTCTGAATCCTCTAGAGATAGAGGCGGCCTTCGGGACAGAGGTGACA GGTGGTGCATGGTTGTCGTCAGCTCGTGTCGTGAGATGTTGGGTTAAGTCCCGCAACGAGCGCAACCCTTGATTTTAGTTGCCAG CACATCATGGTGGGCACTCTAGAATGACTGCCGGTGACAAACCGGAGGAAGGCGGGGATGACGTCAAATCATCATGCCCCTTATG ACTTGGGCTACACACGTACTACAATGGCTGGTACAACGGGAAGCGAAGCCGCGAGGTGGAGCCAATCCTATAAAAGCCAGTCTCA GTTCGGATTGCAGGCTGCAACTCGCCTGCATGAAGTCGGAATTGCTAGTAATCGCGGATCAGCATGCCGCGGTGAATACGTTCCC GGGTCTTGTACACACCGCCCGTCACACCACGAGAGTTTACAACACCCGAAGTCGGTGGGGTAACCCTTACGGGAGCCAGCCGCCG AAAGGGGGGTAAAGC |
| Strain Morphology Photos | |
| Morphological Description | Lychee flesh white;edge serrated;Flattened;slippy;sticky;translucent;Rod;no spore |